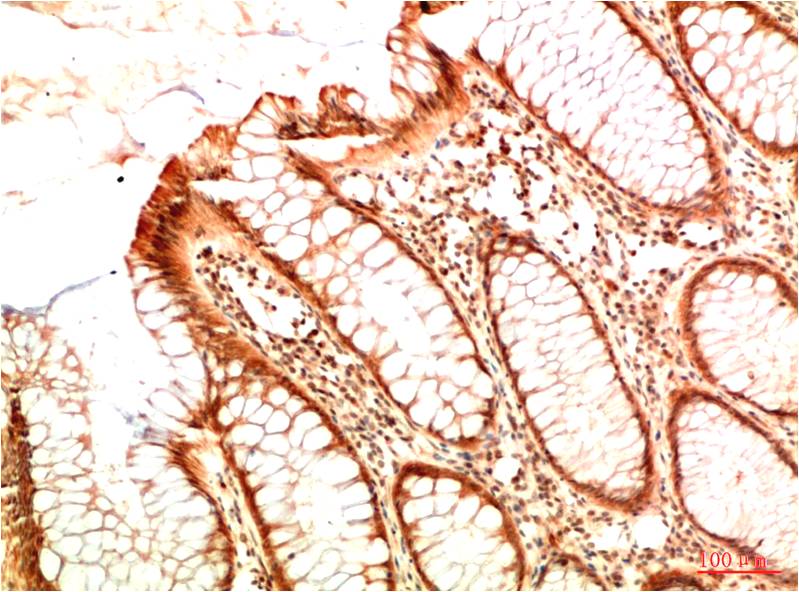

Acetyl P53(K382) Mouse Monoclonal Antibody(5H10)
Catalog NO.:BE3713
Applications :IHC
Reactivity :H,R,M
| 货号 | 规格 | 品牌 | 库存 | 价格 | 数量 | 操作 |
|---|---|---|---|---|---|---|
| BE3713-100 | 100ul | EASYBIO |
|

p53 plays a major role in the cellular response to DNA damage and other genomic aberrations. The activation of p53 can lead to either cell cycle arrest and DNA repair, or apoptosis. Acetylation appears to play a positive role in the accumulation of p53 protein in stress response.
| Product Name: | Acetyl P53(K382) Mouse Monoclonal Antibody(5H10) |
|---|---|
| Isotype: | IgG1 |
| Storage Buffer : | 1mg/ml in PBS, pH 7.4, containing 0.02% sodium azide and 50% glycerol. |
| Storage instructions: | -20°C. Do not aliquot the antibody |
| Recommended dilutions: | IHC: 1:100-200 |
| Optimal dilutions should be determined by the end user. | |
| Specificity: | The Acetyl P53(K382) Mouse Monoclonal Antibody can detects endogenous Acetyl P53(K382) proteins. |
| Alternative Names: | Cellular tumor antigen p53 antibody, Cys 51 stop antibody, Tp53 antibody, Tumor protein p53 antibody |
| Form: | Liquid |
| Reactivity: | H,R,M |
 暂无参考文献!
暂无参考文献!